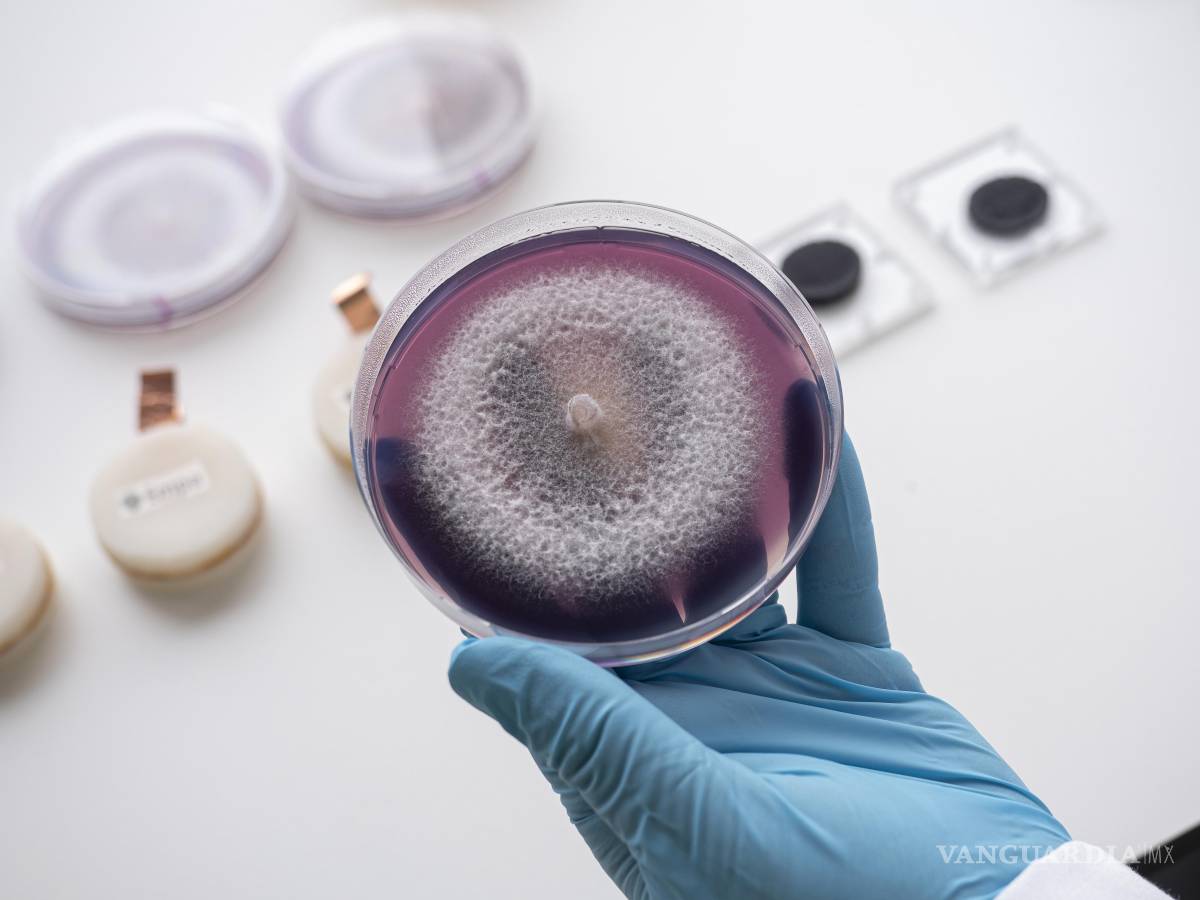
$!Crecimiento de los hongos (en primer plano) utilizados en la batería que necesita alimentación en lugar de cargarse.

Conoce la batería fúngica, hecha con hongos y que se alimenta con materia orgánica

COMPARTIR
Investigadores suizos crearon una batería viviente basada en hongos capaces de generar electricidad y que se e alimenta en vez de cargarse, consumiendo celulosa como nutriente, y se digiere a sí misma desde su interior una vez finalizado su trabajo
Los investigadores de los Laboratorios Federales Suizos de Ciencia y Tecnología de Materiales (Empa) denominan ‘batería fúngica viviente’ a este innovador sistema para acumular energía, ya que se basa en los hongos, “un fascinante reino de la vida, más emparentado con los animales que con las plantas, y que abarca una enorme variedad”, según explican.
En el reino de los hongos se pueden encontrar todo tipo de formas de vida: desde seres comestibles hasta mohos; desde ‘criaturas’ unicelulares hasta algunos de los organismos más grandes de la Tierra; desde patógenos que causan enfermedades hasta ‘superhéroes’ capaces de producir medicamentos, señalan desde el Empa.
TE PUEDE INTERESAR: Conoce la batería que podría poner fin a la era de la gasolina
Los investigadores de este centro suizo han descubierto otra capacidad en los hongos, la de generar electricidad, y la están aprovechando para desarrollar un nuevo tipo de batería, que además de ser ‘fúngica y viviente’, es biodegradable (que se descompone oportunamente por la acción de agentes biológicos y condiciones ambientales) y está impresa con tecnología en 3D, lo que simplifica y agiliza su fabricación.
La mayor ventaja de la batería fúngica funcional, desarrollada por el laboratorio de Celulosa y Materiales de Madera de Empa, es que, a diferencia de las baterías convencionales, no solo es completamente atóxica, sino también biodegradable, según destacan los investigadores.
CÉLULAS VIVAS GENERAN ELECTRICIDAD
Explican que “las células vivas de esta batería no producen mucha electricidad, pero sí la suficiente como para alimentar durante varios días un sensor de temperatura, como los que se utilizan en agricultura o en investigación ambiental”.
Esta batería se basa en una tecnología denominada “celda de combustible microbiana”, que aprovecha la capacidad de los seres vivos (microorganismos, en este caso) de convertir los nutrientes en energía, capturando parte de dicha energía en forma de electricidad.
Hasta ahora, este tipo de celdas venían siendo alimentadas principalmente de bacterias, pero los investigadores de Empa han “combinado, por primera vez, dos tipos de hongos para crear una celda de combustible funcional”, según afirma Carolina Reyes, investigadora de este laboratorio suizo.
DOS TIPOS DE HONGOS EN LOS ELECTRODOS
Los metabolismos (conjunto de reacciones químicas celulares) de las dos especies de hongos se complementan, puntualiza.
En el ánodo (electrodo positivo) de la batería hay una levadura cuyo metabolismo libera electrones, mientras que su cátodo (electrodo negativo) está colonizado por un hongo de podredumbre blanca, que produce una enzima especial que permite capturar los electrones (partículas con carga eléctrica negativa) y conducirlos fuera de la celda.
TE PUEDE INTERESAR: Investigadores de la Universidad de Columbia Británica crean la primera batería elástica y lavable
Reyes explica que “los hongos no se ‘plantan’ en la batería, sino que forman parte integral de la celda desde el principio”.
Los componentes de la batería fúngica se fabrican mediante impresión 3D, lo que permite a los investigadores estructurar los electrodos de forma que los microorganismos puedan acceder a los nutrientes con la mayor facilidad posible, mezclando las células fúngicas con el material de impresión.
“Ha sido muy difícil encontrar un material en el que los hongos crezcan bien y que a la vez pueda pasar fácilmente por la boquilla de la impresora en 3D sin destruir las células fúngicas, y que también sea conductor de la electricidad y biodegradable”, confiesa Gustav Nyström, jefe del laboratorio de Materiales de Celulosa y Madera, de Empa.
Gracias a la amplia experiencia de su laboratorio en la impresión 3D de materiales blandos de origen biológico, los investigadores lograron producir un material adecuado a base de celulosa, una sustancia fundamental de las células y la fibra de las plantas.

“Las células fúngicas incluso pueden usar la celulosa como nutriente, contribuyendo así a la descomposición de la batería tras su uso, pero su fuente preferida de nutrientes son los azúcares simples, que se añaden a las celdas de la batería”, explica Nyström.
“Las baterías fúngicas se pueden almacenar secas y activar in situ simplemente añadiendo agua y nutrientes”, añade Reyes.
Aunque los hongos robustos sobreviven a estas fases secas, trabajar con materiales vivos planteó varios desafíos para los investigadores, que ahora planean aumentar la potencia y la duración de la batería fúngica, así como buscar otros tipos de hongos adecuados para el suministro de electricidad.
“Los hongos aún se investigan y se utilizan poco, especialmente en el campo de la ciencia de los materiales”, coinciden Reyes y Nyström.
DESTACADOS:
- La batería de los laboratorios Empa está impresa en 3D y reúne cuatro características clave que la diferencian de otras tecnologías anteriores: está hecha de materia vida, requiere nutrientes, se degrada de forma natural y carece de toxicidad.
- Las células vivas de la batería fúngica producen la suficiente electricidad como para alimentar durante varios días, los sensores de temperatura que, por ejemplo, se utilizan en la agricultura o en investigaciones ambientales, explican los especialistas suizos.
- La batería fúngica produce pequeñas cantidades de electricidad a partir de dos tipos de hongos; se alimenta tanto de celulosa como de azúcares simples; y puede almacenarse seca y activarse añadiéndole agua y nutrientes, según el Empa.
Por Ricardo Segura EFE-Reportajes.








